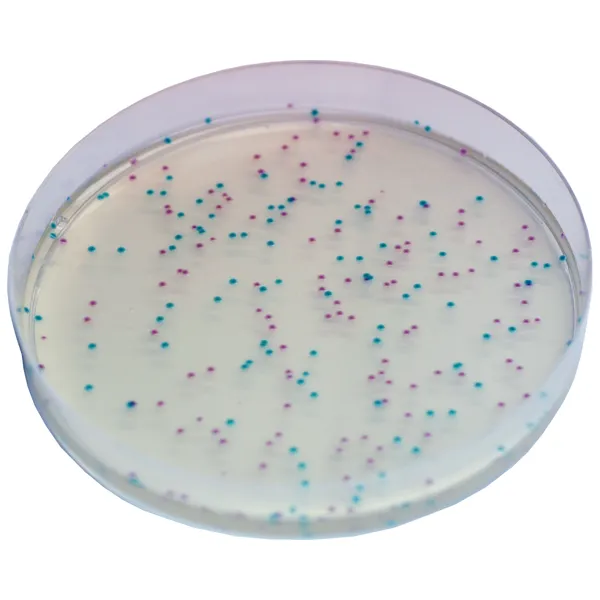
CHROMagar™ ECC

Hình thái khuẩn lạc

E. coli
xanh

Các coliform khác
tím nhạt
Hiệu năng
Hiệu năng
Coliforms, Enterobacteriacae lên men được lactose (lactose positive Enterobacteriacae), là vi khuẩn có mặt trong vi hệ đường ruột người và động vật máu nóng, trong đất và nước. Coliforms là bằng chứng của sự ô nhiễm hữu cơ, môi trường hoặc phân. Ô nhiễm phân, do coliforms từ rác thải động vật, chủ yếu bao gồm Escherichia coli và Klebsiella chịu nhiệt.
Có quy định nghiêm ngặt về sự hiện diện của E. coli/coliform trong mẫu nước và thực phẩm. Điều này có thể giải thích bởi tầm quan trọng của các vi khuẩn này trong xác định độ an toàn của nước và thực phẩm. E. coli có thể làm ô nhiễm nước uống khi hệ thống xử lý nước không đủ hoặc trong các giai đoạn mưa rất nhiều. Theo dõi sản xuất nước và thực phẩm là rất cần thiết. Ô nhiễm cao có thể dẫn đến đình chỉ cung cấp nước và thu hồi thực phẩm bởi các siêu thị.
Tại Hoa Kỳ, các khuyến nghị của EPA thông qua Quy định Total Coliform (TRC) là:
• <1.000 CFU/100 mL cho chất lượng nước câu cá và đi thuyền.
• <100 CFU/100 mL cho chất lượng nước giải trí tiếp xúc cơ thể.
• <1 CFU/100 mL cho chất lượng nước uống.
1. Phát hiện và phân biệt đồng thời: CHROMagar™ ECC cho phép phát hiện và phân biệt đồng thời giữa E. coli và coliform trong một môi trường! Điều này hữu ích để xác định xem có sự ô nhiễm hữu cơ (coliforms) hay ô nhiễm phân (E. coli). Sử dụng kỹ thuật này yêu cầu ít công việc hơn so với các phương pháp truyền thống (MI Agar).
2. Dễ đọc nhờ độ tương phản màu sắc cao giữa các khuẩn lạc. Không có sự trộn lẫn giữa các màu (không giống như một số môi trường chromogen trên thị trường). Khuẩn lạc có màu tím nhạt hoặc xanh (không có màu xanh kim loại hoặc tím).
3. Tiện lợi:Môi trường có thể được sử dụng như một đĩa thạch đã đổ, để phân lập, như hỗ trợ cho các kỹ thuật lọc màng, hoặc được nấu chảy với kỹ thuật đổ.
Thành phần

Tài liệu kỹ thuật
Công bố khoa học
2023
A membrane filtration method for the enumeration of Escherichia coli in bathing water and other waters with high levels of background bacteria
? Publication2023
Dispersal and risk factors for airborne E. coli in the proximity to beef cattle Feedlots
? Publication2001
Trial report : “Comparison between CHROMagar ECC method for the detection and enumeration of Escherichia coli and coliforms and FIL-IDF N°73B: 1998 method for the enumeration of coliforms
? Publication1999
Comparison and recovery of Escherichia coli and thermotolerant coliforms in water with a chromogenic medium incubated at 41 and 44.5°C
? Publication1995
A comparative study of selective media used to detect and confirm coliforms and Escherichia coli in water samples using membrane filtration
? Publication

Xem thêm